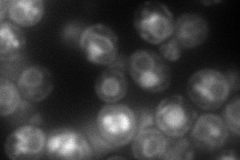
YHR123W
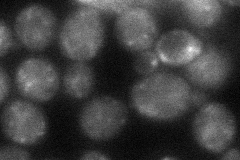
YHR123W
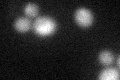
YHR123W

View description
sn-1,2-diacylglycerol ethanolamine- and cholinephosphotranferase; not essential for viability
Localization:
Intensity:
Fold change:
Significance:
-
C’ GFP library in SD

below threshold15.42 -
N' NOP1pr-GFP in SD

ER,punctate54.4497 -
N' TEF2pr-mCherry in SD
ER,vacuole110.01 -
N' NATIVEpr-GFP in SD

ambiguous,punctate27.7447 -
N' TEF2pr-VC and Cyto-VN in SD
punctate40.131 -
C’ GFP library in SD+DTT
cytosol16.521.07No -
C’ GFP library in SD+H2O2

cytosol14.90.96No -
C’ GFP library in Starvation Media

cytosol15.240.98No -
C’ GFP library on the background of Pup2-DaMP

below threshold -
C’ GFP library on the background of CCT mutant

below threshold15.54621.00732No
